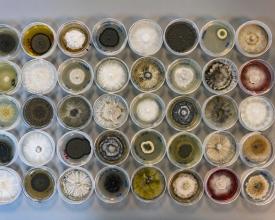

Scalable Model for Sustainable Coffee Farming in Panama

In Panama’s western highlands, small coffee farmers face growing pressures from pests, plant diseases and climate change. Heavy reliance on chemical pesticides has harmed biodiversity, degraded soils and threatened pollinators. This solution shows how endophytic fungi, microorganisms that live naturally inside plants, can serve as effective biological pest control adapted to local conditions. Fungal strains were identified and transformed into low-cost formulations that were tested on coffee farms, where they significantly reduced the need for chemical inputs. The initiative brings together scientists, government institutions and local communities, with a strong focus on training and empowering women farmers. By addressing biodiversity loss, land degradation and gaps in technical capacity, the project strengthens sustainable livelihoods and climate resilience. Farmers benefit through higher yields, lower costs and healthier ecosystems, creating a scalable model for sustainable coffee production in Panama and beyond.
Context
Challenges addressed
- Loss of Biodiversity
- Land and Forest Degradation
- Lack of Alternative Income Opportunities
- Lack of Food Security
- Lack of Technical Capacity
- Poor Monitoring and Enforcement
Location
Process
Summary of the process
The building blocks interact as a continuous pathway that carries innovation from the laboratory to the coffee farm. Scientific research begins the process by uncovering native fungi and developing microbial formulations tailored to Panama’s agricultural conditions. These discoveries gain practical meaning when they are tested in demonstration plots, where farmers can see how the treatments reduce pests, improve plant health, and lessen the need for chemical pesticides. Field results then guide researchers in refining the formulations so they respond to real challenges faced by producers.
Capacity-building activities ensure farmers understand how to apply the new methods and integrate them into their daily practices. Women become key knowledge holders, sharing what they learn and strengthening adoption within their communities. Multi-sector partnerships connect each stage, bringing together government agencies, research institutions, local producers, and international organizations. Through this coordinated effort, scientific advances, community expertise, and policy support come together to create a practical, scalable model for sustainable coffee production in Panama.
Building Blocks
Science-Driven Sustainable Agriculture
The project is grounded in scientific research that explores Panama’s native microbial biodiversity. The project’s microbial formulations were developed with a plan to optimize and re-test the most effective formula for broader adoption. At INDICASAT, researchers identified more than 3,500 strains of endophytic fungi and isolated eight bioactive compounds with antifungal properties. These findings were developed into five microbial formulations designed for pest management in coffee crops. The strains are preserved in Panama’s national microbial biobank, ensuring long-term access to this valuable resource. The scientific team, including award-winning microbiologist Librada Atencio, helped advance the research, which not only supported sustainable agriculture but also revealed two additional compounds with pharmaceutical potential. This scientific foundation enabled the project to create practical, nature-based solutions adapted to local farming conditions where for example the genomic sequencing and metagenomic analysis helped to identify effective bioactive pest control agents. These lab-based solutions were later translated into practical, farmer-friendly products through farmer field schools and demonstration plots.
Enabling factors
• Strong national scientific capacity at INDICASAT and IDIAP made it possible to isolate, sequence, and analyze the fungal strains.
• The existence of Panama’s microbial biobank ensured preservation and long-term access to native strains.
• Support from the Nagoya Protocol Implementation Fund allowed the research to be carried out with a focus on equitable access and benefit sharing.
Lesson learned
• High-quality laboratory work must be closely linked to real farming needs to ensure local applicability.
• Scientific research can generate additional unexpected benefits, such as the discovery of fungi with pharmaceutical potential.
• Recognizing women scientists’ contributions strengthens the visibility and impact of national research teams.
Field Testing and Demonstration Plots
After laboratory development, the microbial formulations were tested on coffee farms in Boquete, Tierras Altas, and Renacimiento. These demonstration plots allowed farmers to observe how the biological treatments performed under real conditions. Producers such as Lourdes Yangüés saw improvements in farm productivity, reduced chemical use, and healthier ecosystems after applying the new formulations. The field trials confirmed that local microbial solutions could effectively address pest pressures while reducing the reliance on synthetic agrochemicals. This hands-on testing built trust among farmers and encouraged broader adoption of sustainable practices.
Enabling factors
• Coffee farms in Boquete, Tierras Altas, and Renacimiento provided diverse, real-world environments for testing microbial formulations.
• Farmer willingness to experiment, motivated by high pesticide costs and environmental concerns, enabled successful trials.
• Collaboration between researchers and producers ensured correct application and monitoring.
Lesson learned
• Demonstration plots build trust where farmers adopt innovations more quickly when they can see results on neighboring farms.
• Biological solutions must be adapted to local conditions, and the success depends on continuous feedback between farmers and researchers.
• Reducing chemical pesticide use can simultaneously lower costs, improve yields, and strengthen ecosystem health.
Community Engagement and Capacity Building
Strong community involvement has been essential to the project’s success. Farmer field schools, workshops, and demonstration activities were used to share knowledge and build local capacity especially for youth and women farmers. A focus on gender inclusion brought more than 600 women into leadership and training activities, enhancing their skills in microbial biodiversity, nature-based pest control, and Access and Benefit-Sharing (ABS). Farmers like Carmencita Tedmann have integrated conservation practices such as maintaining tree cover and improving soil health, and they now share these techniques within their communities. This extensive engagement ensures that new methods are understood, valued, and carried forward by local producers.
Enabling factors
• Farmer field schools created accessible spaces for sharing knowledge and practicing new techniques.
• Strong emphasis on gender inclusion engaged over 600 women, empowering them with leadership and technical skills.
• Traditional knowledge from local communities complemented scientific findings, making solutions culturally and practically relevant.
Lesson learned
• Women’s participation significantly increases adoption and diffusion of sustainable practices within communities.
• Capacity building must be continuous, and farmers need ongoing support as they transition away from chemical inputs.
• Community leadership (farmers teaching farmers) strengthens long-term sustainability and local ownership.
Multi-Sector Partnerships
Collaboration among government agencies, research institutions, international organizations, and farming communities has strengthened every stage of the initiative. MiAMBIENTE, GEF, UNDP, INDICASAT, and IDIAP worked together to integrate scientific research with practical applications in the field. The project became the first in Panama to receive support from the Nagoya Protocol Implementation Fund, reinforcing national capacity to manage genetic resources fairly and sustainably. The partnership also facilitated discussions between researchers and industry regarding the pharmaceutical potential of newly identified compounds. These coordinated efforts ensured that the scientific findings translated into real-world benefits for farmers, ecosystems, and local communities.
Enabling factors
• Collaboration among MiAMBIENTE, GEF, UNDP, INDICASAT, and IDIAP ensured resources, scientific expertise, and policy support.
• Funding from the Nagoya Protocol Implementation Fund strengthened national ABS capacity and provided a unique framework for fair use of microbial resources.
• Engagement with private sector actors opened pathways for potential benefit-sharing related to pharmaceutical discoveries.
Lesson learned
• Multi-sector partnerships accelerate innovation by linking research, policy, and community needs.
• Clear alignment with international frameworks, like the Nagoya Protocol, increases credibility and long-term sustainability.
• Partnerships can generate benefits extending beyond agriculture, such as new opportunities in biotechnology and pharmaceuticals.
Impacts
Environmental Impact: The biological pest management approach reduces chemical pesticide usage, promotes biodiversity conservation, and fosters sustainable farming practices. Any reduction in chemicals could help protect water, soil, and pollinators like bees.
Economic Impact: Coffee farmers reduce input costs by using locally adapted, low-cost pest management methods. This increases their resilience against pests and disease, improving crop yield and farm profitability.
Social Impact: By providing leadership roles for women and empowering youth, the project strengthens social cohesion and supports gender equality in agriculture.
Scientific Impact: The project contributes to global scientific knowledge on the use of bioactive compounds for pest management in agriculture.
By addressing these issues, the project contributes to sustainable coffee production while restoring balance in agro-ecosystems. As a farmer noted:
“Before, we depended on chemicals. Now we are seeing the strength of what our land and our microorganisms can do.”
Beneficiaries
- Women farmers and producers
- Coffee farm owners and workers
- Local research institutions
- Government agencies (MiAMBIENTE, Ministry of Agriculture)
- NGOs and community-based organizations
Global Biodiversity Framework (GBF)
Sustainable Development Goals
Story

Panama is experiencing severe climate change effects, with the highland regions of Chiriquí among the most impacted. Local coffee producers face unpredictable weather threatening their crops and traditional farming.
As one farmer says, “The climate has become unpredictable lately, we must learn new conservation techniques, such as limiting deforestation, planting trees, recycling, and protecting these areas.” Farmers like Carmencita Tedmann in Boquete preserve tree cover, plant shade trees, and improve soil management to protect their farms.
Besides climate challenges, pests and diseases worsen due to deforestation and warming, leading to growing use of chemical pesticides. While effective short term, these chemicals harm the environment, pollute water, and kill pollinators.
A researcher from INDICASAT explains, “It is unfortunate that farmers have to use very strong chemicals that harm the environment, pollute water sources, and destroy pollinators like bees.” Farmers like Lourdes Yangüés in Renacimiento have seen pesticide impacts and shifted to biological pest management, improving yields and sustainability while reducing costs.
The Ministry of Environment of Panama, the Global Environment Facility, and the UNDP partnered with INDICASAT to explore native microbes in agriculture. Combining science with traditional knowledge, the project offers natural solutions that reduce chemical reliance and improve soil and plant health.
This initiative, the first to receive funding from the Nagoya Protocol Implementation Fund, advances the sustainable use of Panama’s rich genetic resources and strengthens the country’s capacity to ensure fair and equitable sharing of benefits arising from their use.
Librada Atencio, joined a national program reintegrating scholars into research institutions paving the way for her to become a permanent researcher. She won the "Women in Innovation" prize for her work in microbiology and biotechnology, including contributions to this initiative.
The project also led to discoveries of two compounds with pharmaceutical potential, opening doors for partnerships between scientists and industry, and benefits for local communities.
Together, these stories demonstrate how collaboration between farmers, scientists, and policymakers is transforming coffee farming in Panama, building resilience, safeguarding biodiversity, and creating a sustainable future for generations to come. As one farmer puts it, “We are learning to work with nature, not against it, to protect our livelihood".